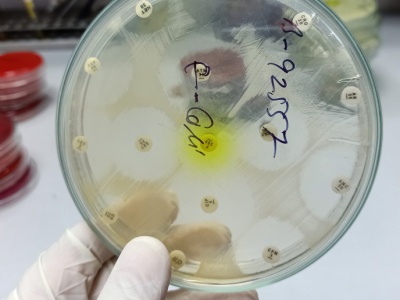

Globalny wzrost oporności na antybiotyki przyspiesza i według ekspertów Światowej Organizacji Zdrowia (WHO) stanowi poważne zagrożenie. Obecnie jedna na sześć infekcji o potwierdzonym podłożu bakteryjnym wywołana jest przez patogen oporny na antybiotyki.
źródło: https://www.rynekzdrowia.pl/Polska-i-swiat/Wyprzedza-postepy-medycyny-Zagrozenie-rosnie-nowy-alarm-ogloszony,277673,15.html
dodano: 07-11-2025 21:45:21
Inne znaleziska:
Duże postępy na budowie wiaduktu nad ul. Mikołowską. Wkrótce pociągi wjadą na nowy obiekt
Duże postępy na budowie wiaduktu nad ul. Mikołowską. Wkrótce pociągi wjadą na nowy obiekt
Trwają intensywne prace na budowie wiaduktu nad ul. Mikołowską. Mieszkańcy przechodzą pod nową konstrukcją, a niebawem górą pojadą pociągi. Pierwsze miesiące po zamknięciu wiaduktu nad ul. Mikołowską upłynęły na przygotowaniach do wyburzenia starego...
katowice24.info
24-07-2025 16:07:05
24-07-2025 16:07:05
Czy polski złoty zareaguje na postępy w rozmowach pokojowych?
Czy polski złoty zareaguje na postępy w rozmowach pokojowych?
Wczorajsze rozmowy w Białym Domu z udziałem Donalda Trumpa, Wołodymyra Zełenskiego oraz przedstawicieli kluczowych państw Unii Europejskiej przyniosły umiarkowany optymizm, choć bez konkretnego przełomu. Liderzy USA, Ukrainy, Europy i NATO podkreślil...
comparic.pl
19-08-2025 12:09:14
19-08-2025 12:09:14
Od USG po badania molekularne. Jak postępy w diagnostyce zmieniły krajobraz leczenia raka endometriu...
Od USG po badania molekularne. Jak postępy w diagnostyce zmieniły krajobraz leczenia raka endometrium
Od USG po genetykę – jak nowoczesna diagnostyka molekularna zmienia podejście do leczenia raka trzonu macicy. Artykuł Od USG po badania molekularne. Jak postępy w diagnostyce zmieniły krajobraz leczenia raka endometrium pochodzi z serwisu Alert Medyc...
alertmedyczny.pl
30-08-2025 01:37:06
30-08-2025 01:37:06
Są postępy przy remoncie zapory Zbiornika Besko. Obiekt jest aktualnie nieprzejezdny
Są postępy przy remoncie zapory Zbiornika Besko. Obiekt jest aktualnie nieprzejezdny
Rzeszów News Zapora Besko przechodzi gruntowną modernizację. Po ponad 25 latach obiekt wymagał remontu zgodnego z najnowszymi standardami bezpieczeństwa. Jeszcze w tym roku przejezdni będą mogli przemieszczać się zmodernizowaną zaporą. Zapora na Jezi...
rzeszow-news.pl
31-08-2025 15:33:09
31-08-2025 15:33:09
Program modernizacji czołgów FV4034 Challenger 2 do standardu Challenger 3 postępuje — część z ośmiu planowanych prototypów przechodzi obecnie kolejne testy i badania poligonowe.
defence24.pl
14-09-2025 10:01:11
14-09-2025 10:01:11
Trump o "owocnej rozmowie" z Xi Jinpingiem. "Osiągnęliśmy postępy"
Trump o "owocnej rozmowie" z Xi Jinpingiem. "Osiągnęliśmy postępy"
Zdaniem prezydenta USA Donalda Trumpa, rozmowa z przywódcą Chin Xi Jinpingiem była "produktywna". Trump zapowiedział wizytę w Chinach w przyszłym roku.
interia.pl
19-09-2025 19:48:39
19-09-2025 19:48:39
Zełenski: Ukraińskie drony skutecznie uderzają w rosyjską logistykę. ONZ komentuje postępy
Zełenski: Ukraińskie drony skutecznie uderzają w rosyjską logistykę. ONZ komentuje postępy
Prezydent Ukrainy Wołodymyr Zełenski podczas szczytu Platformy Krymskiej w ONZ podkreślił, że ukraińskie drony i presja na rosyjską logistykę przynoszą wymierne efekty. Jak twierdzi ukraiński lider, rosyjska machina wojenna napotyka poważne trudności...
wiadomosci.wp.pl
24-09-2025 21:37:11
24-09-2025 21:37:11
Ukraina dołączy do UE? Zełenski i Von der Leyen omówili "postępy"
Ukraina dołączy do UE? Zełenski i Von der Leyen omówili "postępy"
Prezydent Ukrainy Wołodymyr Zełenski i przewodnicząca Komisji Europejskiej Ursula von der Leyen omówili przez telefon "postępy Ukrainy na drodze do członkostwa w UE".
dorzeczy.pl
04-11-2025 00:28:13
04-11-2025 00:28:13
Ukraina traci ważne pozycje. Taktyczne postępy Rosjan okupione są wielkimi stratami
Ukraina traci ważne pozycje. Taktyczne postępy Rosjan okupione są wielkimi stratami
Ukraina mierzy się właśnie z kryzysem wokół trzech ważnych pozycji. Rosjanie dalej napierają i pomimo wielkich strat zdobywają lokalną przewagę na poszczególnych kierunkach. Jeśli natarcie Moskwy będzie dalej postępować, to wiosną 2026 roku Ukraina m...
obserwatorgospodarczy.pl
04-11-2025 15:29:13
04-11-2025 15:29:13
Widziane z orbity: postępy w budowie chińskiego Pentagonu
Widziane z orbity: postępy w budowie chińskiego Pentagonu
Pierwsze informacje na temat postępującej budowy centrum wojskowego Państwa Środka, które zostało okrzyknięte mianem „chińskiego Pentagonu”, pojawiły się na początku bieżącego roku. W ostatnich dniach pojawiły się jednak nowe zdjęcia satelitarne. Wid...
space24.pl
04-11-2025 18:45:17
04-11-2025 18:45:17